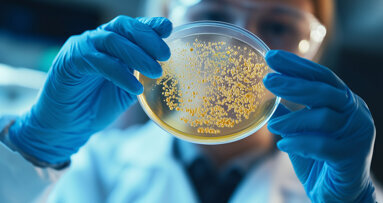
Mikrobiom-Forschung: Speicheltypen als möglicher Risikoindikator

TROISDORF – In dem gerade veröffentlichten Investmonitor des Institutes der Deutschen Zahnärzte ist zu lesen, dass die durchschnittliche Investition für eine Zahnarztpraxisneugründung erneut um 5 % auf 427.000 EUR gestiegen ist und diejenige für eine Praxisübernahme bei immerhin 300.000 EUR verharrt.
Der Deutsche Arbeitskreis für Zahnheilkunde (DAZ) e.V., ein zahnärztlicher Berufsverband, sieht in einer solchen Schuldenlast für den Zahnarzt in seiner Praxis eine unausweichliche Einschränkung der ärztlichen Entscheidungsfreiheit zugunsten von wirtschaftlichen Erwägungen im eigenen Interesse. Die vielfach zu beobachtende Tendenz, schwach vergütete Leistungen der Basisversorgung weniger anzubieten und aufwändigere, teurere Versorgungsformen zu „verkaufen“, hat hier sicherlich einen wesentlichen Grund. Der DAZ hat sich bereits früher für Zurückhaltung bei den Investitionen ausgesprochen und für eine sehr sorgfältige Abwägung zwischen Notwendigkeit und Schnickschnack plädiert. Sehr viele der seitens der Industrie beworbenen, angeblich in der modernen Praxis unverzichtbaren Anschaffungen sind ohne Effekt auf die Ergebnisqualität der Versorgung und auch nicht unabdingbar für die Werbung um Patienten.
Da die Praxen einem ständig steigenden Druck durch von außen aufgezwungene hohe Betriebskosten unterworfen sind, sind niedrige Investitionskosten eine Möglichkeit, sich ein wenig den „Rücken frei zu halten“. In diesem Zusammenhang der über Gesetze und Verordnungen den Praxen auferlegten wachsenden Aufwendungen für Bürokratie und Hygiene fordert der DAZ eine daran orientierte Anpassung der Vergütung für zahnärztliche Leistungen, speziell für die Leistungen, die der Basisversorgung der Bevölkerung dienen. Damit das Anbieten von Basisleistungen – auch für Praxen mit strikter Kostendisziplin – nicht immer höhere Anforderungen an die Selbstlosigkeit der Behandler stellt.
KÖLN - Allein oder gemeinsam, neu oder Übernahme: Eine aktuelle Untersuchung des IDZ zeigt auf, welche Investitionen Existenzgründer im Jahr ...
Chicago – Wer schon einmal beim Eisessen zusammengezuckt ist, kennt das Problem: Plötzlicher Schmerz, der tief in den Zahn zieht. Die Ursache liegt im ...
Hohenheim – Eine einfache Speichelprobe könnte künftig wertvolle Hinweise auf die Zusammensetzung des Magen- und Dünndarm-Mikrobioms liefern – und ...
London – Zahnschmelz ist das härteste Material im menschlichen Körper. Doch wenn er einmal angegriffen ist, gibt es kein Zurück mehr. Ein ...
São Paulo – Ein Naturstoff aus Pflanzen wie Guavenblättern, Äpfeln, Zwiebeln und Feigen könnte vielleicht eines Tages eine neue Waffe gegen ...
Iran – Die Ergebnisse einer aktuellen Metaanalyse zeigen, dass Menschen mit chronisch-entzündlichen Darmerkrankungen ein erhöhtes Risiko für ...
DARMSTADT – Digitale Zahnheilkunde begeistert Anwender weltweit. Das bewies exocad Insights 2018 am 19. und 20. November 2018 in Darmstadt.
KÖLN – Die Internationale Dental-Schau (IDS) 2025 verzeichnet zehn Monate vor ihrer Eröffnung einen starken Ausstellerzuspruch und unterstreicht damit ...
Shimane – Bei der alltäglichen Zahnpflege-Routine denken die wenigsten an ihre Lebenserwartung. Auch nicht daran, ob sie später einmal Hilfe beim ...
München – Bayerns Gesundheits- und Präventionsministerin Judith Gerlach wirbt dafür, dass Kinder schon von klein auf die regelmäßigen ...
Live-Webinar
Di. 23. Juni 2026
2:00 Uhr CET (Berlin)
Live-Webinar
Di. 23. Juni 2026
19:00 Uhr CET (Berlin)
Live-Webinar
Di. 23. Juni 2026
21:00 Uhr CET (Berlin)
Live-Webinar
Mi. 24. Juni 2026
14:00 Uhr CET (Berlin)
Live-Webinar
Mi. 24. Juni 2026
17:00 Uhr CET (Berlin)
Live-Webinar
Mi. 24. Juni 2026
18:30 Uhr CET (Berlin)
Dr. med. dent. Britta Hahn
Live-Webinar
Do. 25. Juni 2026
20:00 Uhr CET (Berlin)
Dr. Hatem Algraffee, Cat Edney



 Österreich / Österreich
Österreich / Österreich
 Bosnien und Herzegowina / Босна и Херцеговина
Bosnien und Herzegowina / Босна и Херцеговина
 Bulgarien / България
Bulgarien / България
 Kroatien / Hrvatska
Kroatien / Hrvatska
 Tschechien & Slowakei / Česká republika & Slovensko
Tschechien & Slowakei / Česká republika & Slovensko
 Frankreich / France
Frankreich / France
 Deutschland / Deutschland
Deutschland / Deutschland
 Griechenland / ΕΛΛΑΔΑ
Griechenland / ΕΛΛΑΔΑ
 Ungarn / Hungary
Ungarn / Hungary
 Italien / Italia
Italien / Italia
 Niederlande / Nederland
Niederlande / Nederland
 Nordic / Nordic
Nordic / Nordic
 Polen / Polska
Polen / Polska
 Portugal / Portugal
Portugal / Portugal
 Rumänien & Moldawien / România & Moldova
Rumänien & Moldawien / România & Moldova
 Slowenien / Slovenija
Slowenien / Slovenija
 Serbien & Montenegro / Србија и Црна Гора
Serbien & Montenegro / Србија и Црна Гора
 Spanien / España
Spanien / España
 Schweiz / Schweiz
Schweiz / Schweiz
 Türkei / Türkiye
Türkei / Türkiye
 Großbritannien und Irland / UK & Ireland
Großbritannien und Irland / UK & Ireland
 International / International
International / International
 Brasilien / Brasil
Brasilien / Brasil
 Kanada / Canada
Kanada / Canada
 Lateinamerika / Latinoamérica
Lateinamerika / Latinoamérica
 USA / USA
USA / USA
 China / 中国
China / 中国
 Indien / भारत गणराज्य
Indien / भारत गणराज्य
 Pakistan / Pākistān
Pakistan / Pākistān
 Vietnam / Việt Nam
Vietnam / Việt Nam
 ASEAN / ASEAN
ASEAN / ASEAN
 Israel / מְדִינַת יִשְׂרָאֵל
Israel / מְדִינַת יִשְׂרָאֵל
 Algerien, Marokko und Tunesien / الجزائر والمغرب وتونس
Algerien, Marokko und Tunesien / الجزائر والمغرب وتونس
 Naher Osten / Middle East
Naher Osten / Middle East

To post a reply please login or register